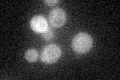
YML111W
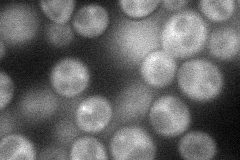
YML111W
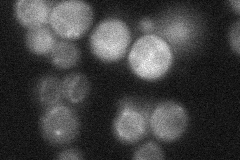
YML111W
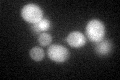
YML111W

View description
Component of the Rsp5p E3-ubiquitin ligase complex, involved in intracellular amino acid permease sorting, functions in heat shock element mediated gene expression, essential for growth in stress conditions, functional homolog of BUL1
Localization:
Intensity:
Fold change:
Significance:
-
C’ GFP library in SD
cytosol25.95 -
N' NOP1pr-GFP in SD
cytosol48.5084 -
N' TEF2pr-mCherry in SD

vacuole0 -
N' NATIVEpr-GFP in SD
cytosol29.4817 -
N' TEF2pr-VC and Cyto-VN in SD

#N/A0 -
C’ GFP library in SD+DTT
cytosol23.910.92No -
C’ GFP library in SD+H2O2

cytosol26.431.01No -
C’ GFP library in Starvation Media

cytosol17.230.66No -
C’ GFP library on the background of Pup2-DaMP

cytosol -
C’ GFP library on the background of CCT mutant

cytosol27.55811.0617No
